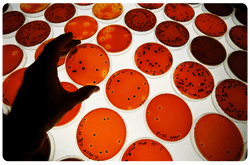
Investigacion

La mayoría de los alimentos son altamente perecederos, pues contienen nutrimentos requeridos para el crecimiento microbiano. Para reducir la descomposición de los alimentos y para prevenir las enfermedades de origen alimentario, la proliferación de microorganismos debe ser controlada. El deterioro del alimento debe ser minimizado para prolongar el tiempo durante el cual un nivel aceptable de características fisicoquímicas y organolépticas puede ser mantenido. Continuar leyendo ¿Qué hace que los microorganismos crezcan?
La mayoría de los alimentos son altamente perecederos, pues contienen nutrimentos requeridos para el crecimiento microbiano. Para reducir la descomposición de los alimentos y para prevenir las enfermedades de origen alimentario, la proliferación de microorganismos debe ser controlada. El deterioro del alimento debe ser minimizado para prolongar el tiempo durante el cual un nivel aceptable de características fisicoquímicas y organolépticas puede ser mantenido. Continuar leyendo ¿Qué hace que los microorganismos crezcan?
Categoría: Alimentos: Ciencia & Desarrollo
Ciencia & Desarrollo
Breve semblanza de la reacción alérgica a los alimentos
 Las reacciones alérgicas a los alimentos son respuestas inmunológicas adversas (hipersensibilidad) al alimento o sus componentes. Estos desórdenes pueden ser divididos a grandes rasgos en aquellos que están mediados por anticuerpos de inmunoglobulina E (IgE) y aquellos que involucran mediadores diferentes. Continuar leyendo Breve semblanza de la reacción alérgica a los alimentos
Las reacciones alérgicas a los alimentos son respuestas inmunológicas adversas (hipersensibilidad) al alimento o sus componentes. Estos desórdenes pueden ser divididos a grandes rasgos en aquellos que están mediados por anticuerpos de inmunoglobulina E (IgE) y aquellos que involucran mediadores diferentes. Continuar leyendo Breve semblanza de la reacción alérgica a los alimentos
Características de los alérgenos más importantes en el huevo
 Los huevos de gallina de la especie Gallus domesticus son conocidos por su potencial para inducir reacciones alérgicas en humanos y las alergias al huevo son una de las más frecuentes en la población. La sensibilización al huevo con subsecuentes síntomas alérgicos en la niñez ocurre con frecuencia sin exposición oral conocida y la frecuencia en niños es 300% mayor que en adultos. Continuar leyendo Características de los alérgenos más importantes en el huevo
Los huevos de gallina de la especie Gallus domesticus son conocidos por su potencial para inducir reacciones alérgicas en humanos y las alergias al huevo son una de las más frecuentes en la población. La sensibilización al huevo con subsecuentes síntomas alérgicos en la niñez ocurre con frecuencia sin exposición oral conocida y la frecuencia en niños es 300% mayor que en adultos. Continuar leyendo Características de los alérgenos más importantes en el huevo
